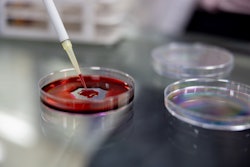
Close-up analyzing blood samples at the laboratory.

The U.S. Food and Drug Administration (FDA) has granted tentative approval to Liquidia Corporation for Yutrepia (treprostinil), an inhaled therapy for adults with pulmonary arterial hypertension (PAH) and pulmonary hypertension associated with interstitial lung disease (PH-ILD). The FDA has found Yutrepia to meet its regulatory standards for quality, safety and efficacy; however, the drug cannot get final approval until a competing product’s regulatory exclusivity expires.
Previously, the FDA approved Tyvaso DPI on May 23, 2022, giving its developer, United Therapeutics, three-year new clinical investigation (NCI) exclusivity. This ruling means Yutrepia could not be marketed until May 23, 2025, at the earliest. Liquidia immediately responded by saying it would appeal the decision on the grounds that this doesn’t fall under the NCI scope, and the company officially filed litigation on Aug. 22, 2024.
“The FDA’s action improperly allows United Therapeutics to tack on yet another regulatory exclusivity, stifling competition and patient choice. This decision violates clear congressional intent to allow NCI exclusivity only for true innovations that are supported by new clinical studies that demonstrate safety and/or efficacy of the innovation,” said Liquidia CEO Roger Jeffs, PhD.
Yutrepia is an inhaled dry-powder formulation of treprostinil. It is administered to patients who have PAH or PH-ILD through a convenient, easy-to-use, palm-sized device. The tentative approval of the FDA is based on results from the phase 3 INSPIRE trial, which were published in Pulmonary Circulation in 2022.